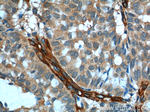
SDPR Antibody in Immunohistochemistry (Paraffin) (IHC (P))
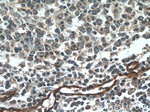
SDPR Antibody in Immunohistochemistry (Paraffin) (IHC (P))
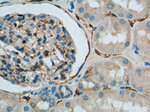
SDPR Antibody in Immunohistochemistry (Paraffin) (IHC (P))

Search
Proteintech
SDPR Polyclonal Antibody
{{$productOrderCtrl.translations['antibody.pdp.commerceCard.promotion.promotions']}}
{{$productOrderCtrl.translations['antibody.pdp.commerceCard.promotion.viewpromo']}}
{{$productOrderCtrl.translations['antibody.pdp.commerceCard.promotion.promocode']}}: {{promo.promoCode}} {{promo.promoTitle}} {{promo.promoDescription}}. {{$productOrderCtrl.translations['antibody.pdp.commerceCard.promotion.learnmore']}}
产品信息
12339-1-AP
种属反应
已发表种属
宿主/亚型
分类
类型
抗原
偶联物
形式
浓度
规格
纯化类型
保存液
内含物
保存条件
运输条件
产品详细信息
This is a rabbit polyclonal SDPR antibody raised against the C-terminus of human SDPR. SDRP of molecular masses 115 kDa and 100 kDa were found in neutrophils, monocytes, lymphocytes, platelets and erythrocytes. In platelets, however, the principal SDRP is a cytosolic protein of molecular mass 68 kDa.
Immunogen sequence: QENQHKMEQ RQISLEGSVK GIQNDLTKLS KYQASTSNTV SKLLEKSRKV SAHTRAVKER MDRQCAQVKR LENNHAQLLR RNHFKVLIFQ EENEIPASVF VKQPVSGAVE GKEELPDENK SLEETLHTVD LSSDDDLPHD EEALEDSAEE KVEESRAEKI KRSSLKKVDS LKKAFSRQNI EKKMNKLGTK IVSVERREKI KKSLTSNHQK ISSGKSSPFK VSPLTFGRKK VREGESHAEN ETKSEDLPSS EQMPNDQEEE SFAEGHSEAS LASALVEGEI AEEAAEKATS RGSNSGMDSN IDLTIVEDEE EESVALEQAQ KVRYEGSYAL TSEEAERSDG DPVQPAVLQV HQTS (73-426 aa encoded by BC016475)
靶标信息
The serum deprivation-response protein (SDPR) is a calcium-independent phospholipid-binding protein whose expression is increased in serum-starved cells. SDPR is a substrate for protein kinase C (PKC) phosphorylation and recruits the polymerase I and transcript release factor (PTRF) to caveolae. Removal of this protein causes caveolae loss and its over-expression results in caveolae deformation and membrane tubulation. Both SDPR and PTRF, as well as the other member of the cavin family PRKCDBP were down regulated in breast cancer cell lines and breast tumor tissue, suggesting that expression of the cavin family proteins could be a useful prognostic indicator of breast cancer progression.
仅用于科研。不用于诊断过程。未经明确授权不得转售。
生物信息学
蛋白别名: Caveolae-associated protein 2; cavin 2; Cavin-2; Phosphatidylserine-binding protein; PS-p68; sdpr; sdpr {ECO:0000312|EMBL:AAH81956.1}; serum deprivation response; serum deprivation response protein; Serum deprivation-response protein; unnamed protein product
基因别名: cavin-2; CAVIN2; PS-p68; SDPR; SDR
UniProt ID: (Human) O95810, (Mouse) Q63918, (Rat) Q66H98
Entrez Gene ID: (Human) 8436, (Mouse) 20324, (Rat) 316384